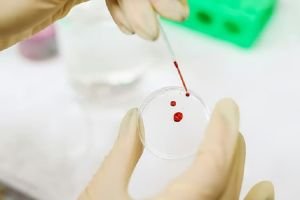

বাবা শব্দটির মধ্যে লুকিয়ে থাকে এক বিশাল আশ্রয়, নিরাপত্তা আর নির্ভরতার অনুভূতি।
২১ জুন ২০২৬ ২১:৪২
বলা হয় পানির অপর নাম জীবন। আর এই…
২৬ মে ২০২৫ ১১:৪৭
ঋতু পরিবর্তনের সময় শরীর সহজেই নানা সমস্যায় আক্রান্ত হয়। যেমন- ঠাণ্ডা-কাশি, হজমের সমস্যা বা ত্বকের অস্বস্তি। এসব থেকে রক্ষা পেতে কার্যকরী একটি প্রাকৃতিক উপাদান হলো…
১৬ মে ২০২৫ ১৯:৫৭
কথায় আছে, আদা সকল রোগের দাদা। আদা কেবল রোগ-প্রতিরোধ ক্ষমতাকেই শক্তিশালী করে না, সেইসঙ্গে ওজন এবং রক্তচাপ কমাতেও সাহায্য করে। আদিকাল থেকেই ওষুধের বিকল্প হিসেবে…
১২ মে ২০২৫ ১২:২৮
থ্যালাসেমিয়া রক্তের এমন একটি রোগ, যা ক্রোমোজোমের মাধ্যমে বংশানুক্রমে পরিবাহিত হয়। আমাদের দেশের প্রায় ১০ শতাংশ মানুষ এ রোগের বাহক। আগামীকাল ৮ মে আন্তর্জাতিক থ্যালাসেমিয়া…
০৭ মে ২০২৫ ২২:৪২
স্বাস্থ্যসচেতনেরা মন দিচ্ছেন জীবনযাপনের ধরন পরিবর্তনে। যাতে ক্যান্সার শরীর থেকে দূরে থাকে। গবেষণা বলছে রান্নাঘরে হাতের কাছে থাকা মশলা ছোট এলাচের ক্যান্সারের সাথে লড়াই করার…
০৩ মে ২০২৫ ২১:৩২